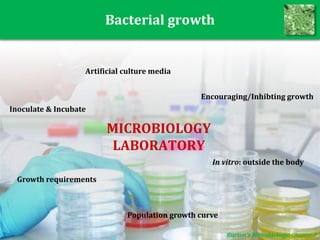
Bacterial growth
Burton’s Microbiology: Chapter 8
Encouraging/Inhibting growth
MICROBIOLOGY
LABORATORY
In vitro: outside the body
Artificial culture media
Growth requirements
Inoculate & Incubate
Population growth curve

This document provides an overview of microbiology concepts including different types of microbes (bacteria, viruses, fungi), bacterial structure and classification. It discusses bacterial morphology, growth and methods of encouraging or inhibiting growth. Specific bacteria mentioned include Salmonella, E. coli, and Rickettsia. Key points covered are bacterial cell structure, the effects of staining techniques, and characteristics used for bacterial identification such as shape, staining properties, nutritional needs, and pathogenicity.